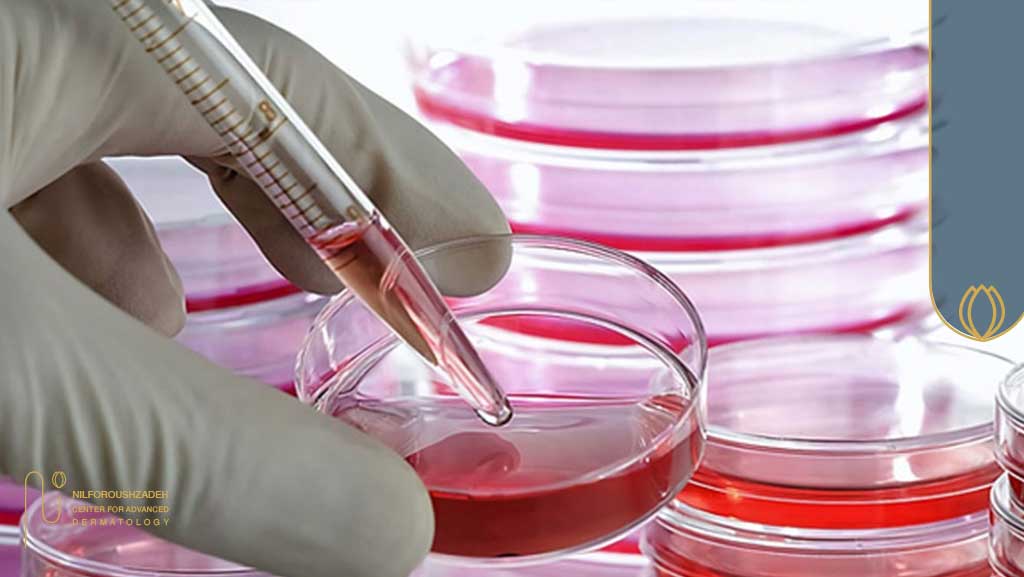
جوانسازی پوست بر پایهٔ علم سلولهای بنیادی

ایران طی سالهای اخیر با پیشرفتهای قابل توجه در حوزه سلولهای بنیادی، مهندسی بافت و پزشکی بازساختی به یکی از مراکز علمی مهم منطقه تبدیل شده است. ایجاد زیرساختهای پژوهشی، تربیت نیروی متخصص و توسعه فناوریهای مرتبط باعث شده دستاوردهای ایران در مقالات معتبر بینالمللی بازتاب گستردهای داشته باشد. در این میان، نقش دانشمندانی که توانستهاند علم پایه را به درمانهای کاربردی و استاندارد تبدیل کنند، اهمیت ویژهای دارد.
در این مسیر، نام پروفسور محمدعلی نیلفروشزاده بهعنوان یکی از تأثیرگذارترین پیشگامان این حوزه شناخته میشود. تمرکز ایشان بر سلولهای بنیادی پوست و مو، مهندسی میکرو محیط بافت و توسعه رویکردهای بازساختی، افق جدیدی در درمانهای مبتنی بر سلول ایجاد کرده است. نتایج پژوهشهای ایشان که در مجلات معتبر منتشر شده، سهم مهمی در ارتقای دانش بازسازی فولیکول مو، ترمیم بافت و کاربردهای بالینی سلولدرمانی داشته است. به همین دلیل، نام ایشان امروز در سطح ملی و منطقهای بهعنوان یکی از بنیانگذاران جریان نوین پزشکی بازساختی مطرح است و نقش او در پیوند پژوهشهای بنیادی با درمانهای بالینی جایگاهی متمایز ایجاد کرده است.
پیشگامان سلولهای بنیادی در ایران و جایگاه ایران در تحقیقات
ایران طی یک دهه اخیر جهشی چشمگیری در پزشکی بازساختی، سلولدرمانی و مهندسی بافت را تجربه کرده و امروز بهعنوان یکی از قطبهای علمی منطقه شناخته میشود. این پیشرفت تنها حاصل توسعه زیرساختها نیست؛ بلکه نتیجهی شکلگیری مراکز تخصصی قدرتمند و حضور اساتید و پژوهشگران پیشرو در این حوزه است.
آنچه ایران را در این مسیر متمایز میکند، همافزایی میان مراکز تحقیقاتی و نقشآفرینی اساتید برجسته در ارتقای استانداردهای پژوهش و درمان است. یکی از چهرههای شاخص این جریان علمی، پروفسور محمدعلی نیلفروشزاده است؛ استاد برجسته درماتولوژی بازساختی که سالها سرپرستی و مشارکت فعال در مراکز تحقیقاتی وپروژههای تحقیقاتی مرتبط با سلولهای بنیادی پوستی، ترمیم بافت، اسکار، زخمها، بیماریهای التهابی پوست و کاربرد لیزرهای بازساختی و ….داشته است.
حضور ایشان در ساختارهای تحقیقاتی باعث شده:
- پروژههای سلولدرمانی پوستی با استانداردهای دقیقتری اجرا شوند
- بسیاری از یافتههای آزمایشگاهی به پروتکلهای بالینی قابلاجرا تبدیل شوند
- مقالات علمی ارزشمند در PubMed منتشر شود که نقش ایران را در سطح بینالمللی پررنگتر کرده
- درمانهای کمتهاجمی و بازساختی در حوزه پوست وارد مرحله کاربرد واقعی شوند
به همین دلیل، مشارکت و هدایتهای علمی پروفسور نیلفروشزاده در این مراکز، نقش مؤثری در ارتقای جایگاه ایران از یک «کشور پژوهشگر» به یک پیشرو منطقهای در پزشکی بازساختی و سلولدرمانی داشته است.همکاریهای پژوهشی پروفسور نیلفروشزاده با مجموعهای از مراکز تخصصی، مسیر توسعه پزشکی بازساختی در ایران را تقویت کرده است.
مراکز کلیدی که نقشی تعیینکننده در این رشد ایفا کردهاند عبارتاند از:
پژوهشگاه رویان:
رویان از اولین پیشگامان سلولهای بنیادی در ایران و خاورمیانه بود که خطوط سلولهای بنیادی جنینی انسانی (hESCs) ایجاد کرد. در حوزه درمانهای بالینی سلولدرمانی (MSCs، سلولهای غضروفساز، سلولدرمانی قلبی و …) پروژههای تأییدشده دارد و پیشرو در تکثیر و تمایز سلولهای بنیادی، مهندسی بافت، تولید سلولهای مزانشیمی و مدلسازی بافتهای پوستی و اندامهای مینیاتوری است.
مرکز تحقیقات سلولدرمانی دانشگاه علوم پزشکی تهران:
فعال در پروژههای مبتنی بر سلولدرمانی بیماریهای پوستی، آسیبهای بافتی، زخمها و کاربردهای کلینیکی MSCs.
مراکز پزشکی بازساختی دانشگاههای علوم پزشکی:
توسعهدهنده پروتکلهای استاندارد برای بازسازی بافت، سلولدرمانی، طب ترمیمی و تولید فراوردههای زیستی.
تمرکز این مراکز بیشتر بر حوزههایی مانند:
• سلولهای بنیادی مزانشیمی (MSCs) بهعنوان پایدارترین و کاربردیترین پلتفرم سلولی در درمانهای پوستی و ترمیمی
• سلولدرمانی بیماریهای پوستی مانند زخمهای مزمن، سوختگی، لکها، اسکارها و ریزش مو
• بازسازی بافتی با بهرهگیری از ماتریکسهای زیستی و فناوریهای مهندسی بافت
• درمان بیماریهای دژنراتیو همچون آرتروز، پارکینسون، دیابت و آسیبهای بافت عصبی
پس آنچه ایران را در این مسیر برجسته کرده، همکاری مؤثر میان مراکز تحقیقاتی برجسته و اساتید مطرح است؛ همکاریای که توانسته پژوهشهای سلولی را از مرحله آزمایشگاه فراتر ببرد و آنها را به روشهای درمانی قابل اجرا تبدیل کند. همین همافزایی علمی، ایران را از یک کشور «فعال در پژوهش» به یک پیشگام منطقهای در پزشکی بازساختی تبدیل کرده است.
بیشتر بخوانید : آیا کاشت مو با سلول های بنیادی امکان پذیر است؟
نقش برجستهٔ پروفسور نیلفروشزاده در پزشکی بازساختی، سلولدرمانی و جوانسازی پیشرفتهٔ پوست و مو
در میان این جریان علمی، نام پروفسور محمدعلی نیلفروشزاده بهعنوان یکی از چهرههای تأثیرگذار پزشکی بازساختی در ایران و منطقه مطرح است. ایشان با سالها فعالیت علمی و پژوهشی در حوزه درماتولوژی بازساختی، سلولهای بنیادی پوستی، ترمیم بافت و کاربرد لیزرهای بازساختی، نقشی مهم در پیوند پژوهشهای بنیادی با درمانهای بالینی ایفا کردهاند.
حضور و مشارکت فعال ایشان در ساختارهای تحقیقاتی موجب شده بسیاری از یافتههای آزمایشگاهی به پروتکلهای بالینی قابلاجرا تبدیل شوند و مقالات علمی متعددی در پایگاههای معتبر بینالمللی منتشر گردد؛ دستاوردی که سهم ایران را در پزشکی بازساختی جهانی پررنگتر کرده است.
حوزههای اصلی پژوهشی ایشان شامل موارد زیر است:
- سلولهای DPC و مهندسی میکرو محیط فولیکول
- اگزوزومهای PRP، AD-MSC و PRF و مشتقات فولیکولی
- لیزرهای بازساختی در جوانسازی و ترمیم بافت
- سلولهای بنیادی پوستی، فیبروبلاستتراپی، بازسازی ماتریکس و درمان اسکار
- ترکیب فناوریهای انرژیمحور با فاکتورهای رشد و سلولدرمانی
این دستاوردها در کنار انتشار دهها مقاله علمی باعث شده پروفسور نیلفروشزاده به یکی از مراجع بینالمللی در بازسازی بافت و درمانهای جوانسازی پیشرفته تبدیل شود.
حوزه جوانسازی پوست بر پایهٔ علم سلولهای بنیادی: بخش مهمی از فعالیتهای ایشان
در کنار تحقیقات گسترده روی فولیکول مو و متدهای انحصاری کاشت مو ایشان، پروفسور نیلفروشزاده از برجستهترین متخصصان ایران در جوانسازی پوست با رویکرد بازساختی محسوب میشود؛ حوزهای که طی سالهای اخیر در مقالات، کارآزماییها و پروتکلهای بالینی ایشان توسعه چشمگیری پیدا کرده است.
مهمترین مسیرهای پژوهشی و بالینی ایشان در جوانسازی پوست عبارتاند از:
• اگزوزومتراپی و MSC-Therapy برای بازسازی درم
افزایش کلاژن I و III، کاهش التهاب مزمن، بهبود ECM و تقویت قوام پوست.
• ترکیب لیزرهای بازساختی با سلولدرمانی
بهبود میکرو محیط بافتی، افزایش نفوذ فاکتورهای رشد و تحریک فیبروبلاستها؛ رویکردی که در چند مقاله ایشان بهعنوان «پروتکل قابلاجرا در کلینیک» معرفی شده است.
• درمان اسکار، چروک و پیری پوستی با پروتکلهای چندمرحلهای
ترکیب لیزر فرکشنال، ساباِندو، سابسیژن، PRP/Exosome و فیبروبلاستتراپی؛ این پروتکلها یکی از امضاهای بالینی ایشان در درمان اسکار و بازسازی پوستاند.
• تحقیقات گسترده روی اسکارهای آتروفیک، هیپرتروفیک، سوختگیها و زخم پای دیابتی
بخشی از این نتایج در مقالات معتبر منتشر شده و اثربخشی واقعی آنها بر کاهش فیبروز و بازسازی ماتریکس ثابت شده است.
• پروتکلهای جوانسازی ترکیبی و کمتهاجمی
از نخستین پژوهشگرانی هستند که نشان دادند ترکیب انرژیهای لیزری و RF با فاکتورهای رشد میتواند پاسخهای بازساختی پوست را بهصورت سینرژیک افزایش دهد. به همین دلیل، در کنفرانسهای علمی بینالمللی از این کارها تحت عنوان Regenerative Aesthetic Protocols یاد میشود.
چرا حضور ایشان در حوزه جوانسازی پوست اهمیت دارد؟
اهمیت نقش پروفسور محمدعلی نیلفروشزاده در جوانسازی پوست، صرفاً به اجرای روشهای درمانی محدود نمیشود؛ بلکه به جایگاه ایشان در طراحی مسیر علمیِ جوانسازی بازساختی بازمیگردد. مسیری که از پژوهش پایه آغاز شده و به پروتکلهای قابلاجرا در کلینیک ختم میشود.
ایشان از معدود متخصصانی هستند که توانستهاند فاصله میان آزمایشگاه و درمان بالینی را بهصورت نظاممند و مبتنی بر شواهد پر کنند. این نقش در چند محور کلیدی قابلتعریف است:
-
طراحی پروتکلهای استاندارد، ایمن و قابلتکرار در محیط کلینیک
پروتکلهایی که نه بر اساس ترندهای زودگذر، بلکه بر پایه دادههای زیستی، مطالعات پایه و نتایج قابلاندازهگیری شکل گرفتهاند. -
ایجاد و توسعه مدلهای حیوانی و آزمایشگاهی
برای آزمودن روشهای ترکیبی جوانسازی، از جمله تلفیق سلولدرمانی، فاکتورهای زیستی و فناوریهای انرژیمحور؛ اقدامی که پیشنیاز اعتبار علمی هر درمان نوین محسوب میشود. -
انتشار مقالات مروری و مفهومی هدایتگر
مقالاتی که صرفاً گزارش نتایج نیستند، بلکه نقشه راه آینده جوانسازی بازساختی را ترسیم میکنند و جهتگیری پژوهشهای بعدی را مشخص میسازند. -
مشارکت فعال در پروژههای ترمیم زخم، سوختگی و اسکار
حوزهای که پایهایترین و واقعیترین شکل جوانسازی محسوب میشود، زیرا بازسازی عملکردی بافت را پیش از زیبایی ظاهری هدف قرار میدهد. -
ترجمه یافتههای آزمایشگاهی به درمانهای بالینی روزمره
بسیاری از پروتکلهایی که امروز در کلینیکهای پیشرفته مورد استفاده قرار میگیرند، نتیجه همین نگاه ترنسلیشنال و مبتنی بر شواهد هستند.
بازسازی مو؛ حوزه محوری و متمایز فعالیتهای پژوهشی ایشان
در کنار جوانسازی پوست، بازسازی مو با رویکرد سلولی و بازساختی یکی از مهمترین و متمایزترین حوزههای فعالیت علمی پروفسور نیلفروشزاده به شمار میرود. حوزهای که طی سالهای اخیر با انجام مطالعات پایه، مدلهای حیوانی و انتشار مقالات در پایگاههای معتبر جهانی، به یکی از شاخصترین مسیرهای تحقیقاتی ایشان تبدیل شده است.
ایشان از نخستین افرادی در ایران هستند که بازسازی مو را نه بهعنوان یک فرآیند جابجایی فولیکول، بلکه بهعنوان یک پدیده زیستی قابلمهندسی مورد مطالعه قرار دادهاند.
بیشتر بخوانید : کاشت مو با سلولهای بنیادی روش بازساختی پروفسور نیلفروشزاده
محورهای اصلی پژوهشی و بالینی در بازسازی مو با تمرکز بر سلولهای بنیادی
| محور پژوهشی | تمرکز سلولی / زیستی | اهمیت در بازسازی مو |
|---|---|---|
| سلولهای درمال پاپیلا (DPCs) | حفظ و افزایش قابلیت القایی (Inductivity)، بازگردانی عملکرد تریژنیک و سیگنالدهی سلولی | هسته اصلی فولیکولوژنز و بازسازی واقعی فولیکول مو؛ هدف کلیدی درمانهای بازساختی نوین |
| فولیکولسازی آزمایشگاهی | ترکیب سلولهای DPC با سلولهای اپیتلیال در مدلهای حیوانی | تشکیل فولیکول جدید؛ گام مستند بهسوی فولیکولوژنز انسانی |
| اگزوزومتراپی و PRP / AD-MSC | اگزوزومهای مشتق از Outer Root Sheath، سلولهای بنیادی مزانشیمی مشتق از چربی (AD-MSC) و PRP | افزایش تکثیر DPC، فعالسازی مسیرهای ورود به فاز آناژن، تقویت عملکرد القایی و زیستی فولیکول مو |
| مهندسی میکرومحیط فولیکولی (Follicular Niche Engineering) |
ماتریکس خارجسلولی (ECM)، بیومواد، فاکتورهای رشد، سیگنالینگ مولکولی و شرایط کشت | طراحی محیط بهینه برای القای فولیکول جدید و افزایش پایداری عملکرد سلولی |
| مسیرهای آناژن / کاتاژن | تعاملات سلولی و مولکولی سلولهای بنیادی فولیکولی |
تعیین ورود فولیکول به فاز رشد یا استراحت؛ پایه علمی درمانهای بازسازی مو پس از سال ۲۰۲۵ |
سوالات متداول (FAQ)
DPC Activation دقیقاً چیست؟
تحریک و تقویت سلولهای پاپیلای درمی برای هدایت چرخه رشد مو. این سلولها «مغز فولیکول» هستند و فعالسازی آنها یکی از نوآوریهای بازسازی مو ۲۰۲۵ است.
Niche Engineering چیست؟
Niche Engineering یا مهندسی ریزمحیط سلولی به اصلاح و بهینهسازی محیط اطراف سلولها اشاره دارد؛ از جمله ماتریکس خارجسلولی (ECM)، فاکتورهای رشد و مسیرهای سیگنالینگ. هدف این رویکرد افزایش توان بازسازی سلولها در پوست و فولیکول مو و بازگرداندن عملکرد زیستی طبیعی آنهاست.
نقش پروفسور محمدعلی نیلفروشزاده در پزشکی بازساختی چیست؟
پروفسور محمدعلی نیلفروشزاده یکی از چهرههای اثرگذار پزشکی بازساختی در ایران و منطقه بهشمار میرود. پژوهشهای ایشان در حوزه سلولهای بنیادی پوست، ترمیم بافت، مهندسی نیش فولیکولی و DPC Activation در مجلات معتبر علمی بینالمللی منتشر شده و پایهگذار توسعه متد نیلفروش بودهاند.
تمرکز اصلی تحقیقات ایشان بر چه حوزههایی است؟
محورهای پژوهشی و بالینی ایشان شامل بازسازی و جوانسازی پوست، درمان اسکارهای پیچیده، سلولدرمانی در آسیبهای پوستی، ترمیم زخمهای مزمن از جمله زخم پای دیابتی و نکروزها، لیزرهای بازساختی، اگزوزومتراپی، MSCهای مشتق از چربی و فولیکول، و استراتژیهای فولیکولسازی آزمایشگاهی و مهندسی بافت مو است.
متد نیلفروش چه تفاوتی با روشهای رایج دارد؟
این متد بر ترکیب چند تکنیک بازساختی (سلولدرمانی، اگزوزوم، لیزرهای بازساختی، مهندسی محیط سلولی) استوار است و بهجای درمان سطحی، هدف آن فعالسازی سلولهای هدف مانند DPC و MSC برای بازسازی واقعی بافت است.
همکاریهای تحقیقاتی پروفسور نیلفروشزاده چگونه است؟
ایشان همکاری علمی مستمری با مراکزی مانند پژوهشگاه رویان، دانشگاههای علوم پزشکی و دانشگاه شهید بهشتی داشتهاند. این همکاریها در چارچوب پزشکی ترجمانی (Translational Medicine) به انتقال نظاممند یافتههای آزمایشگاهی به پروتکلهای بالینی قابل اجرا منجر شده است.
مرکز تحقیقاتی تحت سرپرستی ایشان چه ویژگیهایی دارد؟
این مرکز بهصورت مستقل بر حوزههایی مانند سلولهای بنیادی پوست، مدلسازی و مهندسی بافت، ترمیم زخم، لیزرهای بازساختی و توسعه محصولات مبتنی بر MSC و اگزوزوم تمرکز دارد و بخشی از شبکه مراکز پزشکی بازساختی کشور محسوب میشود.
چه چیزی پروفسور نیلفروشزاده را متمایز میکند؟
تمایز اصلی ایشان در تمرکز همزمان بر سه لایه مکمل است: پژوهش سلولی (مطالعات in vitro و مدلهای حیوانی)، طراحی پروتکلهای بالینی قابل اجرا، و توسعه ترکیبات نوین سلولی–لیزری که در بسیاری از مراکز مشابه دیده نمیشود. این همپوشانی پژوهش و درمان، هسته اصلی اثرگذاری علمی ایشان را شکل میدهد.